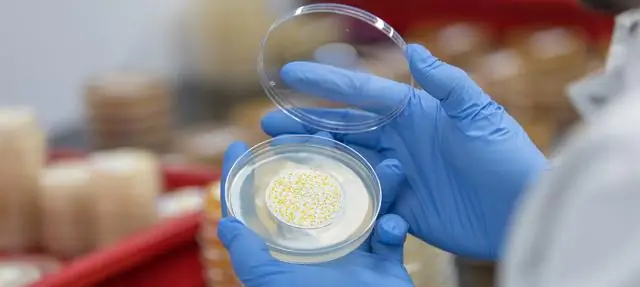
Ассортимент продукции дополнен новым 2-компонентным конструкционным клеем

Клей Благодаря своей особенно хорошей адгезии к композитам, металлам и различным пластмассам, стабильный 2-компонентный метакрилатный конструкционный клей открывает новые возможности с точки зрения конструкции и сопряжения материалов. Типичные значения прочности на сдвиг при растяжении составляют 25 Н / мм². Несмотря на высокую жесткость 780 Н / мм², Ergo.1675 обладает очень хорошей ударной вязкостью с удлинением при разрыве 85%. Это свойство обеспечивает поглощение напряжений, вызванных большими различиями в тепловом расширении различных материалов, или постоянную компенсацию вибраций. Структурный клей 10: 1 обеспечивает идеальную форму даже при высоких температурах. При 80 ° C более 50% начальной прочности все еще достигается. Быстрое наращивание прочности до прочности руки обеспечивает эффективное время обработки при серийном производстве. В течение пяти минут достигается прочность до 10 Н / мм². В ходе разработки особое внимание было уделено охране труда. Новый клей почти не имеет запаха и трудно воспламеняется. Это доступно в стандартных двойных картриджах 10: 1 или различных больших контейнерах. (Qui)
Вы также можете быть заинтересованы в:
Подсказка к книге
Практичные конструкции и применения, подходящие для клея
Совет: встреча пользователей облегченной конструкции На 3-й встрече пользователей облегченной конструкции, которая состоится в Вюрцбурге с 4 по 5 декабря 2018 года, участники смогут узнать больше о концепции, структуре, материале и производстве облегченной конструкции. В этом году основное внимание будет уделено бионике, композитным материалам, аддитивному производству и подходящим технологиям соединения.
Дополнительная информация: встреча пользователей для облегченной конструкции